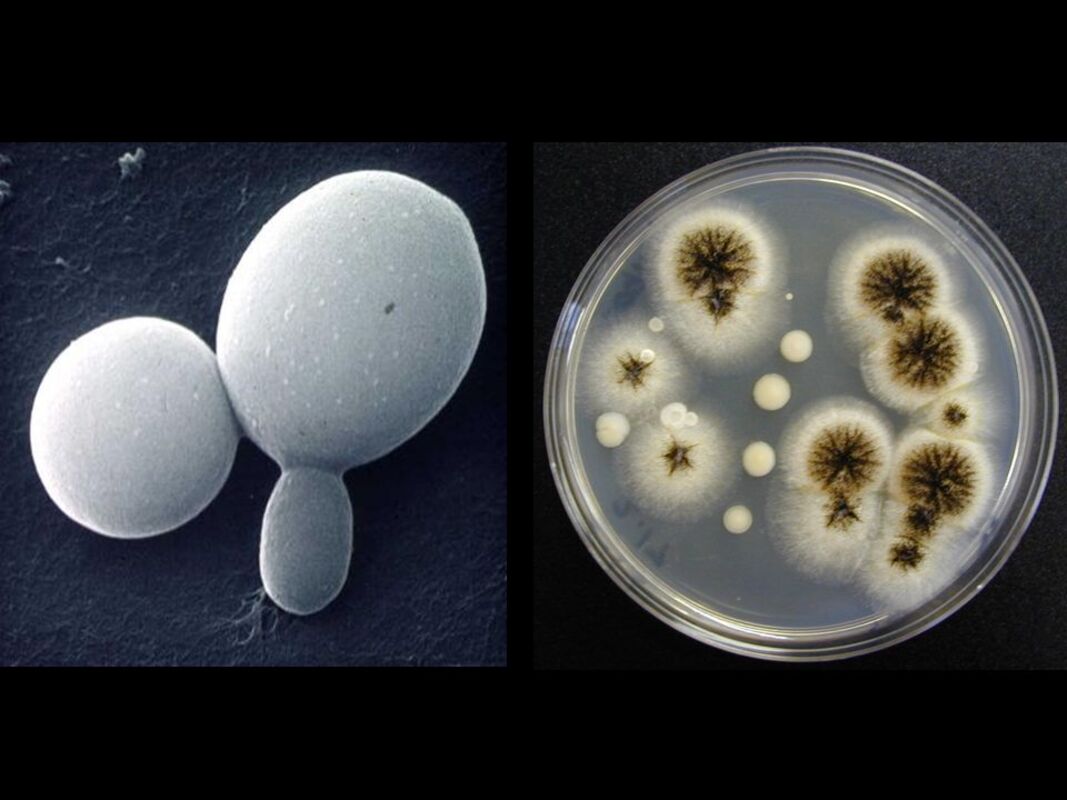
Биология грибков и связанные с ними заболевания

Растущая во всем мире заболеваемость и смертность от грибковых инфекций, в том числе вызванных классическими или (повторно) возникающими патогенами, представляет собой серьезную проблему общественного здравоохранения.
Существует острая необходимость в осуществлении обязательного информирования об этих забытых грибковых заболеваниях, а также в солидных инвестициях в новые эффективные диагностические и терапевтические альтернативы для улучшения контроля микозов. В этом контексте ученые в последнее время сосредоточились на расшифровке нескольких аспектов грибковых клеток, включая энергетический метаболизм, клеточный цикл, экспрессию генов, протеостаз, функцию митохондрий, ответ на стресс, секреторные пути и внутренние или приобретенные механизмы резистентности.
Поэтому для данного обзора мы пригласили экспертов поделиться своими последними результатами по биологии грибов: (i) метаболизм и реакция на изменения окружающей среды; (ii) модели инфекции и вирулентности in vivo; (iii) экспрессия и регуляция генов; (iv) метагеномика и диагностика; (v) стратегии борьбы с грибковыми инфекциями.
Будучи многогранными организмами, грибковые организмы адаптируются к окружающей среде, претерпевая метаболические и морфологические изменения. Fabri et al. описали механизмы, вовлеченные в реакцию теплового шока (ТШ), связанную с ультраструктурными изменениями клеточной стенки и контролем целостности клеточной стенки (ЦКС) у Aspergillus fumigatus. Фактически, экспрессия HsfA и hsp90 необходима для адаптации грибов к стрессу в биопленках Aspergillus. HsfA, в свою очередь, регулирует экспрессию генов ответа на ТШ и гомеостаз клеточной стенки и липидов, демонстрируя свою центральную роль во взаимодействии ТШ и перекрестного пути регуляции ЦКС для термофилии A. fumigatus.
Адаптация к температуре была также изучена Almeida et al. на термически диморфном грибе Histoplasma capsulatum. Сравнительная протеомика показала, что мицелий обильно экспрессирует ферменты гликолитического пути и спиртового брожения, что указывает на преимущественное использование анаэробных путей для производства энергии, тогда как дрожжевые клетки экспрессируют белки цикла трикарбоновых кислот и ТШ-ответа. Кроме того, различная экспрессия ферментов ответа на окислительный стресс или метаболизма клеточной стенки по-разному регулировала состав этой структуры в двух морфологиях H. capsulatum.
Poirier et al. исследовали метаболическую адаптацию грибов, в частности, пути катаболизма у видов Scedosporium, включая деградацию консервативных ароматических промежуточных соединений. Авторы предсказали несколько кольцерасщепляющих диоксигеназ в геноме Scedosporium, которые были подтверждены определением уровней экспрессии генов кластера гентизиновой кислоты, сверхэкспрессированных в присутствии лигнина (или гентизиновой кислоты) и обеспечивающих экологическую адаптацию грибов.
Ключевым аспектом экологической адаптации и размножения нитчатых грибов является правильное образование спор. Микопатогенный гриб Trichoderma производит хламидоспоры, которые имеют огромные преимущества перед конидиями в плане биотехнологического применения. Peng et al. сообщили о временном транскриптомном анализе и дифференциальной экспрессии генов во время формирования хламидоспор у Trichoderma virens, уделяя особое внимание правильному синтезу хитина для клеточной дифференциации.
Характеристика вирулентности грибов и ответа хозяина на инфекцию необходима для описания новых терапевтических средств против грибов. Криптококковая инфекция зависит от экспрессии нескольких детерминант вирулентности. Несмотря на хорошие характеристики, экспериментальные мышиные модели криптококкоза не имитируют заболевание человека, и относительно мало что известно об этой инфекции у людей. de Sousa et al. провели обзор современных процедур, используемых для изучения вирулентности Cryptococcus sp. у человека, ассоциации и корреляции клинических данных пациентов и характеристики вирулентности грибков и взаимодействия хозяин-патоген, указав на важность международного сотрудничества и интеграции данных для преодоления трудностей и ускорения развития знаний о криптококкозе человека.
При рассмотрении грибковых патогенов и моделей растений известно, что виды из рода Fusarium заражают огромное количество хозяев, в которых связанные с ними заболевания трудно контролировать. Damodaran et al. оценили применение микопатогена Trichoderma reesei для борьбы с фузариозным увяданием бананов, показав значительное снижение тяжести заболевания. Этот эффект, возможно, связан с увеличением производства противогрибковых соединений и снижением производства токсинов Fusarium.
Говоря о характеристике экспрессии вирулентности грибов, следует отметить, что семейство генов агглютининоподобной последовательности (ALS) видов Candida, включая Candida parapsilosis, представляет собой важный класс детерминант вирулентности. Однако из-за высокой идентичности последовательностей и доли тандемных повторов правильная сборка этих локусов с помощью высокопроизводительного секвенирования обычно недостижима. Oh et al. использовали смешанный подход, применяя Oxford Nanopore MinION, Illumina MiSeq и секвенирование по Сэнгеру, чтобы полностью раскрыть семейство генов ALS у C. parapsilosis. Также были проведены qRT-PCR анализы для оценки экспрессии каждого гена ALS в C. albicans, C. dubliniensis, а также C. parapsilosis, что выявило сложную картину экспрессии генов семейства ALS.
Для создания эффективной терапии грибковых инфекций необходима правильная идентификация этиологического агента. Классические методики основаны на культуральной и микроскопической оценке, которая занимает много времени, часто неспецифична и лишена чувствительности. Описание методик секвенирования нового поколения, включая длинные прочтения, при более низкой стоимости может ускорить специфическую идентификацию патогенов в клинических образцах. Hoang et al. обсуждают плюсы и минусы внедрения этих методик в рутинную диагностику микозов.
Наконец, понимание реакции хозяина и предложение новых терапевтических стратегий может помочь более эффективно бороться с грибковыми инфекциями. Araújo et al. описали, как прием глюкокортикоидов влияет на пролиферацию C. neoformans и его капсульную структуру, что приводит к худшему исходу инфекции в животных моделях, включая более высокую грибковую нагрузку на органы и сокращение времени выживания, и может дополнительно объяснить клинические неудачи в условиях иммунокомпрометированных пациентов.
С другой стороны, Granato et al. характеризуют противогрибковое действие 1,10-фенантролин-5,6-диона (фендиона) и его комплексов на основе металлов против Phialophora verrucosa. Продемонстрировав аддитивный эффект по отношению к амфотерицину В, эти препараты оказывают сильное воздействие на биопленки P. verrucose, а их способность снижать инфицирование макрофагов и грибковое бремя в моделях Galleria mellonella подтверждает их многообещающий терапевтический потенциал.
В целом, материалы данного обзора охватывают многие неизученные аспекты биологии грибов, направленные на разработку новых методов лечения и диагностики, включая новые методологии сайленсинга и секвенирования генов, омические методы и подходы к разработке лекарств.